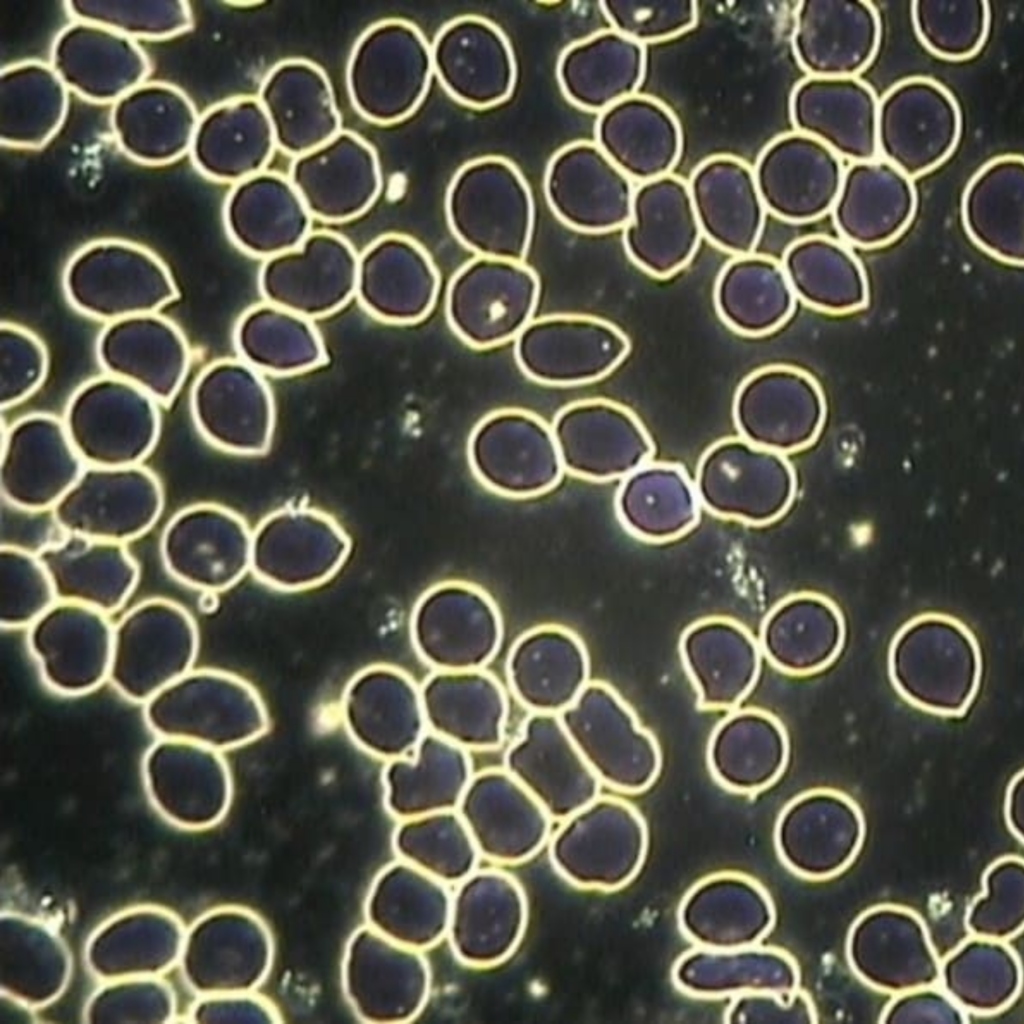
Free-flowing blood cells after being exposed to quantum energy technology

Leading biohacker Dave Asprey has spent years asking hard questions about human health, searching for real answers. So when he sat down with Quantum Upgrade founder Philipp von Holtzendorff-Fehling and asked what the single most convincing piece of data was that quantum energy directly affects human biology, he wasn’t looking for a theory.
Philipp’s answer more than delivered on Dave’s question because there’s not a single piece of evidence, there’s three. For Philipp, a former VP at T-Mobile who saw firsthand the effects of 4G, 5G, and EMFs, the three most significant implications for human biology are in the blood, the cells, and the brain.
You can watch their full interview on Dave’s YouTube channel.
Three independent lines of research, each measuring something different, arrived at the same conclusion: quantum energy exposure produces measurable, reproducible changes in the human body.
Blood doesn’t lie. Its behavior under a microscope is immediate, visible, and measurable. That’s why dark field microscopy has become one of the most compelling tools for studying the effects of quantum energy on human biology.
Healthy blood flow depends on something called the zeta potential, which is the electrical charge that keeps red blood cells separated and moving freely. When that charge is disrupted, cells become sticky. They stack into what researchers call “rouleaux” formations, or money-roll patterns, and clump together. This is bad for your cells because it impairs oxygen transport, slows circulation, and compromises your body’s ability to clear waste.
Exposure to electromagnetic fields (EMFs) is one of the stressors known to reduce zeta potential, and thus cause red blood cells to form these rouleaux.
However, several studies done with both Quantum Upgrade and Leela Quantum Tech’s technology showed that quantum energy can reverse that damage to red blood cells in real time. Using darkfield microscopy, researchers observed that exposure to quantum energy technology visibly dissolved clumping within minutes, restoring the zeta potential and returning cells to free-flowing movement. Microcirculation also improved and oxygen transport became more efficient.
But the blood findings went beyond red blood cells. In separate studies, researchers also tracked:
Think about what blood actually does: it carries oxygen to your organs, fuel to your muscles, and immune cells to wherever they’re needed. When red blood cells are clumping together, none of that happens efficiently.
You’re not recovering as fast or thinking as clearly. Your body is working harder to do less. The research showed that quantum energy exposure reversed that clumping in minutes and restored the kind of free-flowing circulation your body needs to function at its best.

Every cell in your body runs on one fuel: adenosine triphosphate, or ATP. It powers healing, cognition, physical performance, and immune response. Without sufficient ATP, the body’s ability to maintain, repair, and defend itself is compromised. Which makes it one of the most important biological markers researchers could choose to study.
In a double-blind study designed to explore the effects of quantum energy on cellular function, cells exposed to quantum energy via Quantum Upgrade showed ATP production increases of 20% to 29%. This jump was:
The downstream effects were just as notable. In wound-healing trials using Human Dermal Fibroblasts, the technology accelerated cellular recovery by 45.8% to 100%, a direct demonstration of what happens when cells have more energy to work with.
Longer-term exposure (30 to 120 days) revealed further effects: a measurable shift toward more efficient oxidative energy metabolism, and a mitochondrial network that showed greater resilience under stress conditions.
ATP is what your body runs on. Every time you heal a cut, fight off an infection, focus on a problem, or push through a workout, you’re spending ATP. When your cells produce more of it, you have more in reserve for all of those things.
The 20–29% increase observed in this research isn’t a rounding error, it’s the difference between a body that’s scraping by on its energy budget and one that has something left over. That surplus is what recovery, resilience, and performance are built on. The fact that this effect was achieved remotely, across 500 miles, using no physical contact or device, is what makes this study so difficult to explain away.
Your brain generates electrical patterns continuously. Those patterns tell a precise story about your neurological state. Stress, focus, relaxation, and hyperarousal each have distinct brainwave signatures. Research now shows that 5G radiation measurably disrupts them—and that Quantum Upgrade’s technology restores them.
The study testing Quantum Upgrade on brainwave activity (using electroencephalography, or EEG included multiple participants under three different conditions:
The 5G-only condition caused measurable neurological disruption, with stress and hyperarousal waves (beta and gamma) significantly higher. Brainwaves associated with relaxed alertness and meditative focus (alpha and theta) were suppressed.
With Quantum Upgrade active during the 5G exposure, however, those same brainwaves returned to levels comparable to the no-exposure baseline. It helped return the brain to its natural regulatory state.
Most people know what stress feels like. They recognize the mental noise, the difficulty winding down, the sense that your body is on alert even when there’s nothing to respond to. What this research shows is that 5G radiation can put your brain into exactly that state without you being aware of it.
Those stress signatures show up in the EEG data whether you feel them or not.
Equally significant is that Quantum Upgrade reversed those signatures without having to remove the 5G radiation. It restored the brain’s own regulatory patterns in the presence of the 5G radiation. The brain wasn’t protected from the signal, it just wasn’t destabilized by it. That’s a meaningful distinction.


Blood morphology, cellular energy, and brainwave activity are distinct biological domains. Researchers studying one aren’t necessarily looking at the others. Yet, across all three areas, findings point toward the same underlying principle.
Quantum energy doesn’t appear to force a specific biological outcome. Instead, it produces what researchers call a coherence pattern. It’s a signal that biological systems can orient toward, allowing them to self-organize back toward a higher state of order.
Blood cells that were clumping begin to flow freely. Mitochondria that were underperforming begin to produce more energy. A brain that was registering stress begins to return to coherence. In each case, the body isn’t being overridden, it’s being supported.
Research behind Quantum Upgrade spans three of the most fundamental indicators of how well the human body is functioning: blood health, cellular energy production, and neurological coherence. And these studies were conducted using double-blind protocols, independent researchers, and measurable, reproducible outcomes.
Quantum Upgrade works remotely, via quantum entanglement, which is the same non-local interaction principle recognized by the Nobel Prize in Physics in 2022. Once your unique identifier is entered into the system, you’re in the field. There’s nothing to wear, plug in, or carry. It works whether you’re at home, traveling, or going about your day.
If you’re curious what that looks like in practice, give Quantum Upgrade a try. It runs in the background of your life, supporting your blood, your cells, and your brain whether you’re aware of it or not.
The single most convincing piece of evidence for quantum energy isn’t how it affects one body part. It’s how it affects your entire biology.
Share

Disclaimer:
Quantum Upgrade® does not recommend or endorse any specific tests, physicians, procedures, opinions, or other information that may be mentioned on this website. Reliance on any information appearing on this website is solely at your own risk. Statements made on this site have not been evaluated by the Food and Drug Administration (FDA), the EFSA, or any other government derivatives thereof. Quantum Upgrade® products are not intended to diagnose, treat, cure, or prevent any disease or health condition.
On this website, the word “healer” does not refer to a physician or medical professional and it does not relate to the conventional way of helping others with medical treatments, pharmaceutical drugs, etc. Here a “healer” rather refers to how this word was used hundreds and thousands of years ago: someone that seeks to help by means other than conventional medical treatment. This may involve the use of herbs, minerals, crystals, and other natural elements. It can certainly also involve the use of various energetic techniques, working with the quantum field, the source, as well as specific frequencies and vibrations.
© 2026 Quantum Upgrade | All rights reserved